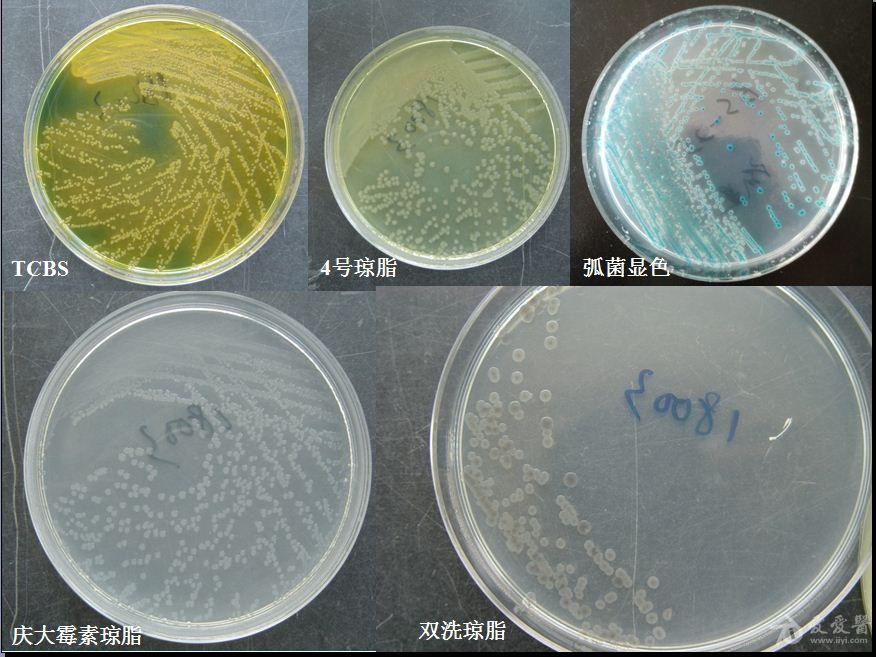
霍乱弧菌菌落形态图片及检测流程

霍乱弧菌革兰染色

霍乱弧菌的革兰氏染色
图片尺寸810x536
霍乱是一种急性的分泌性腹泻疾病,由革兰阴性菌霍乱弧菌的产毒菌株
图片尺寸879x962
丁香园论坛 - 专业医生社区,医学,药学,生命科学,科研学术交流
图片尺寸980x736
关于图中所示霍乱弧菌的特点,下列哪项是错误的 ( )
图片尺寸332x250
霍乱弧菌菌落形态图片及检测流程
图片尺寸3264x2448
霍乱弧菌
图片尺寸288x300
关于图中所示霍乱弧菌的特点,下列哪项是错误的()
图片尺寸324x571
霍乱弧菌检验方法及结果判断
图片尺寸964x964
霍乱弧菌菌落形态图片及检测流程
图片尺寸2048x1536
霍乱弧菌核酸检测试剂盒(冻干型,恒温荧光法)
图片尺寸300x300
霍乱弧菌菌落形态图片及检测流程
图片尺寸1536x2048
今日热点 > 内容 结果:霍乱弧菌为革兰氏阴性菌,呈弧形或弯曲状,染色
图片尺寸412x412
弧菌弧菌霍乱弧菌细菌照片
图片尺寸400x300
霍乱菌照片
图片尺寸450x300
霍乱弧菌菌落形态图片及检测流程
图片尺寸876x657
霍乱弧菌菌落形态图片及检测流程
图片尺寸2048x1536
24小时后霍乱弧菌在血平板上为灰白色,β溶血的菌落(图3,4),革兰染色
图片尺寸660x660
关于图中所示的霍乱弧菌,叙述正确的是()
图片尺寸440x634
霍乱弧菌电镜照片
图片尺寸350x239
实战经验大分享——霍乱弧菌现形记!
图片尺寸462x257